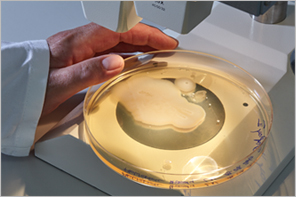
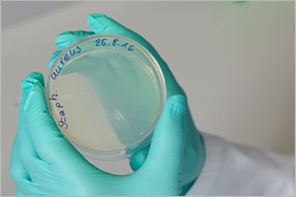
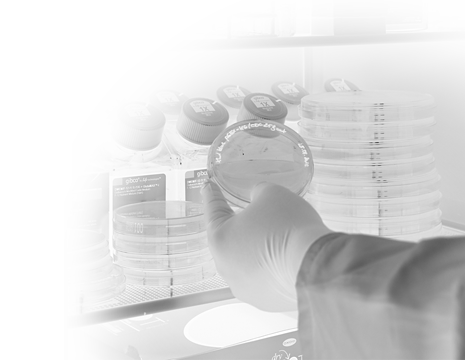

Herzlich willkommen!

Sicherer Umgang mit Biostoffen
Ein wichtiges Thema im mikrobiologischen Labor!
Wer mit Biostoffen oder gentechnisch veränderten Organismen arbeitet, muss das mögliche Gefährdungspotenzial der Stoffe und Agenzien sowie die wirksamen Schutzmaßnahmen kennen.
Dieses Lernprogramm
- informiert Sie über die Grundregeln guter mikrobiologischer Technik,
- stellt Ihnen weitere Hygienemaßnahmen für den Umgang mit Biostoffen und gentechnisch veränderten Organismen der Risikogruppe 2 vor,
- gibt Ihnen Tipps, wie Sie sich wirksam schützen können.
Investieren Sie 20 Minuten Zeit. Es lohnt sich.
Starten Sie mit der Playtaste die Präsentationen
oder wechseln Sie mit den Pfeiltasten auf eine andere Seite.

Harmlos oder nicht?
- Infektiös?
- Sensibilisierend?
- Toxisch?



Kennen Sie das Gefährdungspotenzial und die Schutzmaßnahmen?









Dieses Lernprogramm informiert Sie über
- Grundregeln der „Guten mikrobiologischen Technik“ = GMT
- zusätzliche Hygienemaßnahmen
ab Risikogruppe 2 - Tipps zum Gesundheitsschutz
Investieren Sie 20 Minuten Zeit.
Es lohnt sich.



- Beim Umgang mit Biostoffen und gentechnisch veränderten Organismen gelten je nach Gefährdungsbeurteilung abgestufte Schutzmaßnahmen.
- Zu den Biostoffen zählen gemäß Biostoffverordnung Mikroorganismen (auch gentechnisch veränderte), Zellkulturen, humanpathogene Endoparasiten oder TSE auslösenden Agenzien (Prionen).
- Eine gute Hygienesituation im Sinne einer „guten mikrobiologischen Technik“ ist die Basis für eine sichere Arbeit im Biolabor!
- Allgemeine Schutzmaßnahmen werden bei Bedarf durch weitere Maßnahmen, z.B. bei toxischer und sensibilisierender Wirkung des Biostoffs, ergänzt.
- Die überwiegende Anzahl der Beschäftigten arbeitet in Biolaboren der Schutz- bzw. Sicherheitsstufen 1 und 2. Beim Umgang mit Biostoffen höherer Risikogruppen sind weitergehende Schutzmaßnahmen einzuhalten!
- Planen Sie für das Durcharbeiten des Lernprogramms ca. 20 Minuten ein.